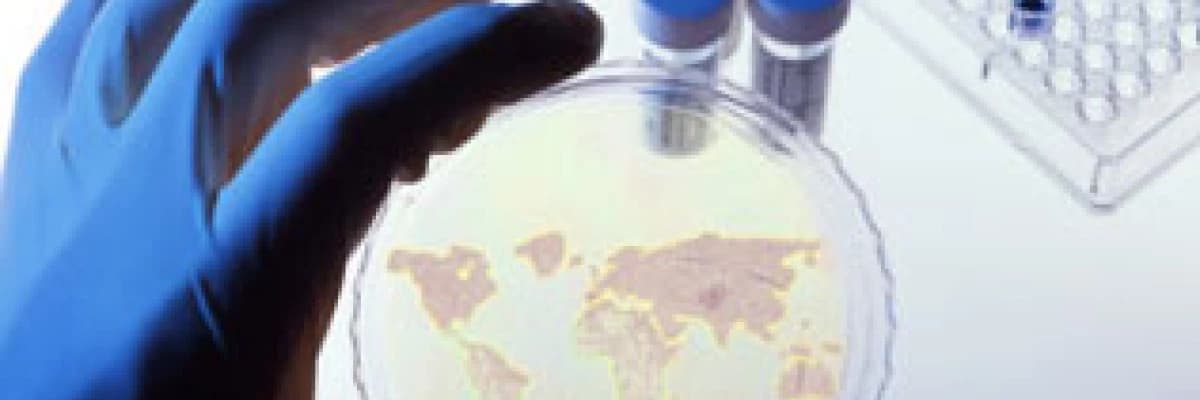
Beta mikrobu nedir ?

Beta mikrobu nedir ?

İçerik yapay zeka ile optimize edilmiştir
Beta Mikrobu Nedir?
A Grubu Beta Hemolitik Streptokok, halk arasında bilinen adıyla Beta mikrobu, doğada yaygın olarak bulunan bir mikroorganizmadır. Bu mikrop, basit cilt iltihaplarından farenjite, hatta hayati risk taşıyan şok tablolarına kadar geniş bir yelpazede hastalıklara yol açabilmektedir.
Toplumun yaklaşık %15 ile %20'sinin boğazında herhangi bir şikayete neden olmadan bulunan bu mikroba sahip kişilere taşıyıcı denir. Taşıyıcılık geçici bir durumdur; ancak farenjit geçiren bireylerin %20'si, tedaviye rağmen belirli bir süre taşıyıcı kalmaya devam edebilir.
Beta Mikrobu Nasıl Bulaşır?
Beta mikrobu esas olarak kişiden kişiye temas yoluyla bulaşır. Bulaşma süreci genellikle şu yollarla gerçekleşir:
- Çocuklar arasındaki oyunlar sırasında gerçekleşen yakın temas,
- Öpüşme,
- Gıdalar aracılığıyla bulaşma.
Özellikle kreş, yuva ve okul gibi kalabalık ortamlar, mikrobun yayılmasını ciddi oranda kolaylaştıran faktörler arasındadır.
Beta Mikrobunun Neden Olduğu Hastalıklar
A Grubu Beta Hemolitik Streptokoklar vücutta farklı klinik tablolara sebebiyet verebilir. Bu mikroorganizmanın neden olduğu başlıca hastalıklar şunlardır:
- Beta Farenjiti: Boğaz enfeksiyonları.
- Kızıl Hastalığı: Farenjit ile birlikte görülen karakteristik deri döküntüleri.
- Cilt Enfeksiyonları: Sellülit, lenfanjit ve piyodermi gibi yara enfeksiyonları.
- İnvaziv Beta Enfeksiyonu: Kas ve derin dokulara kadar ilerleyen şiddetli enfeksiyonlar, bakteriyemi ve toksik şok.
Beta Mikrobu Neden Tehlikelidir?
Beta enfeksiyonları çocukluk çağında sık görülür ve vücudun bu mikroba verdiği yanıt bazen çok şiddetli olabilir. Bu kontrolsüz bağışıklık yanıtı, hayati organlarda kalıcı hasarlara yol açabilir:
- Romatizmal Ateş: Kalp, eklem ve sinir sistemini etkileyen, kalıcı hasarlarla seyreden bir tablodur.
- Glomerulonefrit: Vücudun verdiği şiddetli tepki sonucu oluşan ciddi böbrek harabiyetidir.
Beta Farenjiti ve Belirtileri
Özellikle 3-15 yaş arası çocuklarda ve sonbahar ile ilkbahar arasındaki okul döneminde sık görülür. Çocuklardaki farenjit vakalarının %40'ından, erişkinlerde ise %10'undan Beta mikrobu sorumludur. Hastalık şu belirtilerle kendini gösterir:
- Ani başlayan boğaz ağrısı ve yüksek ateş,
- Baş ağrısı, bulantı ve karın ağrısı,
- Muayenede kızarık, şiş ve akıntılı boğaz yapısı,
- Şişmiş lenf bezleri ve tonsiller (bademcikler).
Teşhis, boğaz kültürü veya hızlı tanı testleri ile konulur. Antibiyotik tedavisinin temel amacı; mikrobun temizlenmesi, komplikasyonların önlenmesi ve hastalığın süresinin kısaltılmasıdır.
Beta Enfeksiyonu Komplikasyonları
Beta enfeksiyonu iki farklı tipte komplikasyona yol açabilir:
| Komplikasyon Türü | Açıklama |
|---|---|
| Yayılma Kaynaklı | Tedavisiz kalan farenjit; sinüzit, otit (kulak iltihabı), menenjit ve zatürreye yol açabilir. |
| Bağışıklık Kaynaklı | Mikrobun organlarla benzerliği sonucu oluşan Romatizmal Ateş ve Glomerulonefrit tablosudur. |
Romatizmal Ateş: Tedavi edilmemiş vakalarda 3-4 hafta sonra ortaya çıkar. Eklemlerde ağrı, şişme ve kalıcı kalp kapağı hasarlarına neden olabilir.
Glomerulonefrit: Enfeksiyondan yaklaşık 1 ay sonra başlar. Göz çevresinde şişme, ödem, kanlı idrar ve yüksek tansiyon ile seyreder. Vakaların %95'i iyileşirken, %5'inde kalıcı böbrek hasarı kalabilir.
Kızıl Hastalığı
Beta mikrobunun salgıladığı toksinlere karşı gelişen aşırı hassasiyet durumudur. Göğüsten başlayıp vücuda yayılan, zımpara kağıdı hissi veren kırmızı döküntülerle karakterizedir. Bu tabloda dil çilek görünümü alır. Tedavi genellikle antibiyotiklerle başarılı bir şekilde sonuçlanır.
Tedavi Yöntemleri
Beta mikrobu penisiline karşı oldukça hassastır. İlk 9 gün içinde başlanan tedavi, romatizmal ateşi tamamen, glomerulonefriti ise büyük oranda engeller.
Önemli Not: Romatizmal ateş ve glomerulonefrit geliştiğinde, bu durum mikrobun kendisinden ziyade vücudun tepkisi olduğu için antibiyotik değil; aspirin ve kortizon gibi ilaçlar tercih edilir.
Taşıyıcıların Tespiti ve Önemi
Okul ve kreşlerdeki salgınları önlemek için taşıyıcıların tespiti kritiktir. Aile içinde sürekli tekrarlayan enfeksiyonlara pin-pon enfeksiyon denir. Normalde her taşıyıcı tedavi edilmez; ancak aşağıdaki durumlarda tedavi zorunludur:
- Salgın riski mevcutsa,
- Ailede romatizmal ateş veya glomerulonefrit öyküsü varsa,
- Aile içinde sürekli tekrarlayan (pin-pon) enfeksiyonlar görülüyorsa,
- Yakın çevrede kızıl hastalığı tespit edilmişse.
Taşıyıcılar, boğazdan alınan örneklerin kültürü ile tespit edilir. Tedavide genellikle depo penisilin iğnesi veya ağızdan alınan antibiyotikler kullanılır.